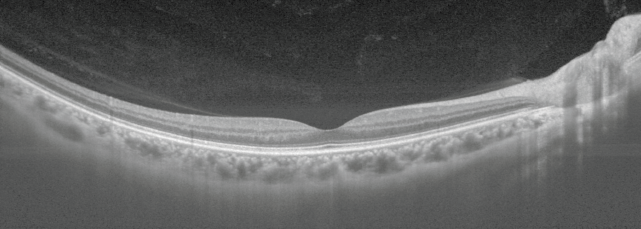

DRI OCT TRITON 2
DRI OCT Triton 2 je naslednja generacija multimodalne Swept Source optične koherentne tomografije, in fundus kamera z novim načinom fotografije Slit-scan.
Ključne funkcije
✔ Swept-Source OCT z visoko gostoto skeniranja in globoko penetracijo
✔ Slit-scan tehnologija za zajem slike skozi majhne zenice (φ2,0 mm ali več*¹)
✔ Širokokotna OCT in OCTA – do 21 mm*²
✔ Smart Denoise*² zagotavlja višje razmerje med signalom in šumom pri 3D OCT in
OCTA*²
✔ Prilagodljivo pozicioniranje za lažje zajemanje slik
✔ Poenostavljen potek dela z brezhibno integracijo za hitro analizo in nadaljnje
spremljanje
✔ Povezava z IMAGEnet7
*1 Potrjeno s testnim očesom
*2 Opcija
Novi DRI OCT Triton2 podjetja Topcon Healthcare združuje napredno Swept Source OCT tehnologijo s pravo-barvno fundus kamero.
TEHNOLOGIJA SWEPT SOURCE OCT
Hitrost skeniranja 100.000 A-skenov/sek omogoča zajem gostega niza jasnih B-skenov, saj v danem času pridobi več A-skenov.
To pomaga zmanjšati artefakte, ki nastanejo zaradi nehotenih premikov oči, kot so sakade in mežikanje.
NOVA SLIT-SCAN FOTOGRAFIJA
Inovativna slit-scan osvetlitev in rolling-shutter mehanizem v napravi Triton2 omogočata izjemno kakovostne barvne posnetke očesnega ozadja z manj bleščanja in senc.*3
Slit-scan mehanizem pomaga premagati enega od pogostih vzrokov za slabše ocenjene slike, saj omogoča učinkovito slikanje tudi skozi majhne zenice.
Ta inovativna tehnologija pomaga napravi Triton2 zajeti ostre, visokokakovostne slike očesnega ozadja ne glede na miozo ali osvetlitev, kar ni mogoče s konvencionalnimi fundus kamerami.

JASEN PREGLED DEBELIN MREŽNICE IN ŽILNICE
IMAGEnet7 omogoča do 5 zemljevidov debeline mrežnice, kar omogoča kvantifikacijo mrežnične plasti in podplasti.
Triton2 zagotavlja jasno vizualizacijo žilnice in ustvarja zemljevide debeline žilnice, kar podpira klinično razumevanje strukturnih sprememb žilnice.

IZBIRNA FUNKCIJA TOPCON SS OCT ANGIOGRAPHY
Izbirna funkcija Topcon SS OCT Angio™ združuje OCT angiografijo s Swept Source tehnologijo in dolgo valovno dolžino 1050 nm.
Z algoritmom OCTARA™, lastniškim postopkom za obdelavo slik, omogoča podrobno vizualizacijo žilnih struktur in spremljanje ključnih patologij mrežnice.


ŠIROKOKOTNO SLIKANJE
Opcijski širokokotni nastavek omogoča zajem skenov do 21 mm dolžine.
Omogoča več kliničnega vpogleda z wide-field OCT in OCTA slikanjem, kar je zelo uporabno pri številnih očesnih boleznih.

MOZAIČNA SLIKA

DIAGNOSTIČNE ZMOŽNOSTI
SMART DENOISE*4
Smart Denoise je algoritem za obdelavo slik, ki zmanjšuje artefakte in povečuje kontrast.
Z uporabo Topconovega edinstvenega AI algoritma se iz vsakega B-skena znotraj gostih podatkovnih kock ustvarijo visokokakovostne OCT in OCTA slike z zmanjšanim šumom.

FUNKCIJA PONOVNEGA ZAJEMA(Follow-Up Function)
Funkcija ponovnega zajema omogoča enostavno ponovno pridobivanje in ponovno analizo iste lokacije, kar omogoča nemoteno primerjavo preteklih in trenutnih podatkov. Operaterji preprosto izberejo prejšnje podatke skeniranja, Triton2 pa samodejno zajame ustrezno območje.

GLAVKOM
*5 Primerjava diagnostične zmožnosti glavkoma med širokopoljskimi zemljevidi RNFL s swept-source OCT in spectral-domain OCT
Won June Lee, Ki Ho Park et al., Eye, letnik 32, 2018
Diagnostična natančnost širokopoljskega zemljevida s swept-source optično koherentno tomografijo pri primarnem odprtokotnem glavkomu pri kratkovidnih očeh
Yong Woo Kim, Jinho Lee, Jin-Soo Kim, Ki Ho Park, AJO, 2020
*6 Donald C. Hood, PhD, Translational Vision Science & Technology, št. 6, letnik 3, 2014: Evalvacija enostranskega poročila za pomoč pri odkrivanju glavkomske okvare.
*7 En sam širokopoljski OCT-protokol lahko zagotovi prepričljive informacije za diagnozo zgodnjega glavkoma
Donald Hood et al., Translational Vision Science & Technology, 2016
ANTERIOR SEGMENT
DRUGE FUNKCIJE
CELOVITA POROČILA
POVEZLJIVOST
IMAGEnet7 je skladen s standardom DICOM, kar omogoča enostavno integracijo s sistemi PACS in programi elektronskih zdravstvenih kartotek (EMR).

Opazovanje in fotografiranje očesnega ozadja (fundusa)
| Vrsta fotografiranja | Barvna / Infrardeča svetloba (IR) |
| Vidni kot | 50° ±5% |
| Delovna razdalja | 35,5 mm ±0,1 mm |
| Premer zenice za fotografiranje | φ2,0 mm ali več |
| Ločljivost slike očesnega ozadja (na mrežnici) | Barvna:
Infrardeča (IR):
IR fotografiranje se uporablja samo za poravnavo območja slikanja, ne za ustvarjanje slike fundusa. |
| Merilno območje dioptrijske moči | -33 D do +40 D Brez kompenzacijske leče: -13 D do +12 D S konkavno lečo ¹: -33 D do -12 D S konveksno lečo ¹: +11 D do +40 D |
Opazovanje in zajem tomografske slike očesnega ozadja
| Obseg skeniranja (na fundusu) | Vodoravno: 3–12 mm ±5% Navpično: 3–12 mm ±5% |
| Vzorec skeniranja | 3D skeniranje / Linearno skeniranje (črtno, križno, radialno) |
| Hitrost skeniranja | 100.000 ±5.000 A-skenov na sekundo |
| Stranska ločljivost | 20 μm |
| Globinska ločljivost | Optična: 8 μm, Digitalna: 2,6 μm ±3% |
| Premer zenice za fotografiranje | φ2,5 mm ali več |
Sistem fiksacijskih tarč
| Notranja fiksacijska tarča | Matrični prikaz z organskim LED zaslonom (položaj in način prikaza nastavljiva) |
| Periferna fiksacijska tarča | Prikazana glede na položaj notranje tarče |
| Zunanja fiksacijska tarča | Vključena |
| Merilno območje dioptrijske moči (oko pacienta) | Brez kompenzacijske leče: -13 D do +12 D S konkavno lečo ¹: -33 D do -12 D S konveksno lečo ¹: +11 D do +40 D |
Opazovanje in fotografiranje sprednjega segmenta očesa ³
| Vrsta fotografiranja | Infrardeča svetloba (IR) |
| Delovna razdalja | 17 ±0,3 mm |
Opazovanje in zajem tomografske slike sprednjega segmenta ³
| Delovna razdalja | Vodoravno: 3–16 mm ±5% Navpično: 3–16 mm ±5% |
| Obseg skeniranja (na roženici) | 3D skeniranje / Linearno skeniranje (črtno, radialno) |
| Vzorec skeniranja | 100.000 ±5.000 A-skenov na sekundo |
| Hitrost skeniranja | Zunanja fiksacijska tarča |
| Fiksacijska tarča | 10,5 ±0,5 mm |
Opazovanje in zajem širokokotne tomografske slike očesnega ozadja ⁴
| Delovna razdalja | 10,5 ±0,5 mm |
| Obseg skeniranja (na fundusu) | Vodoravno: 21 mm ±10% (63,4° ±8%) Navpično: 21 mm ±10% (63,4° ±8%) |
| Vzorec skeniranja | 3D skeniranje / Linearno skeniranje (črtno, križno, radialno) |
| Hitrost skeniranja | 100.000 ±5.000 A-skenov na sekundo |
| Stranska ločljivost | 30 μm |
| Globinska ločljivost | 8 μm |
| Merilno območje dioptrijske moči (oko pacienta) | Brez kompenzacijske leče: -7 D do +40 D S konkavno lečo ¹: -33 D do -5 D |
Električne specifikacije
| Električne specifikacije | 100–240 V AC |
| Frekvenca | 50–60 Hz |
| Poraba energije | 130 VA |
Dimenzije in teža
| Dimenzije | 321–454 (Š) × 523–664 (G) × 573–657 (V) mm |
| Teža | 24,3 kg ±10% |
¹ Samodejno ostrenje in ročno ostrenje z delilnimi črtami nista na voljo pri uporabi konkavne ali konveksne kompenzacijske leče.
² Velja samo za opazovanje in zajem tomografije očesnega ozadja.
³ Opazovanje in fotografiranje sprednjega segmenta očesa sta mogoča samo z dodatnim kompletom za sprednji segment AA-1.
⁴ Opazovanje in fotografiranje širokokotne tomografije fundusa je možno samo z dodatno širokokotno OCT lečo WA-1.
















